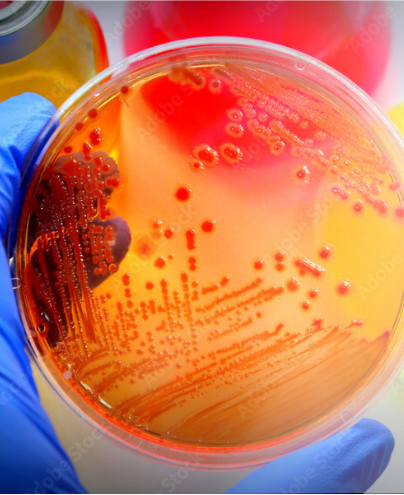

Puromycin
純度98%超え・エンドトキシンフリー
豊富な使用文献数が証明する『選ばれる選択用抗生物質』
希望販売価格
26,000円
メーカー略号:ING
品番:ANT-PR-1
容量:100 MG(10×1 ML)

バルクサイズなど、様々な容量をご用意しております。お気軽にお問い合わせください。
Puromycin とは
Puromycin(ピューロマイシン)は、真核生物と原核生物の両方に作用する選択用抗生物質です。
Streptomyces alboniger という放線菌由来のアミノヌクレオシド系化合物で、遺伝子導入や形質転換体の選別に幅広く利用されています。
Puromycin は、細胞内のタンパク質合成を阻害することで、耐性遺伝子を持たない細胞を迅速に死滅させます。
Puromycin はグラム陽性細菌、動物細胞、昆虫細胞に対して高い効果を示し、遺伝子工学や分子生物学の研究において、信頼性の高い選別ツールとして多くの研究者に使用されています。

Puromycin の作用機序と耐性遺伝子
Puromycin(ピューロマイシン)は、リボソームに結合し、ペプチジルトランスフェラーゼ反応を阻害することで、タンパク質合成を停止させます。その結果、細胞内でのタンパク質形成が中断され、細胞は死滅します。
Puromycin への耐性は、pac 遺伝子によって付与されます。この遺伝子は Streptomyces 属の放線菌から分離されたもので、N-アセチルトランスフェラーゼ(PAC)という酵素をコードしています。
この酵素の働きにより、pac 遺伝子を持つ細胞は Puromycin に耐性を持ち、形質転換体の選別が可能になります。
Puromycin の仕様
・製品濃度:10 mg/ml(溶液)
・CAS 番号:58-58-2
・エンドトキシンレベル:< 5 EU/mg
・純度:≥ 98 % (HPLC)
・Ready-to-use
・組成式:C22H29N7O5・2HCl
・分子量:544.3
・構造式

品質管理
安定した品質を保つため、ロット間のばらつきがないことを徹底的にテストし、品質の一貫性を確保しています。
物理化学的特性
pH測定、外観検査により、製品の物理化学的な特性が厳密に管理されています。
細胞培養試験済み
Puromycin に対する感受性と耐性を持つ哺乳類細胞株で、有効性が検証されています。
微量汚染物質の非細胞毒性
Puromycin 耐性細胞において、長期的な影響を与えないことが確認されています。
Puromycin のワーキング濃度
哺乳類細胞における Puromycin の推奨濃度は1〜10 µg/mlです。実験の初期段階では、ホスト細胞を効果的に死滅させるための最適な濃度を確認することをおすすめします。
Puromycin は、pac 遺伝子を持たない真核細胞を迅速に死滅させます。死滅した細胞は培養プレートから剥がれ落ちるため、形質転換クローンの早期かつ簡単な特定が可能です。
以下に、哺乳類細胞での推奨濃度をいくつか示します。
| 細胞 | 培地 | 濃度 |
|---|---|---|
| B16 (Mouse melanocytes) | RPMI | 1-2 µg/ml |
| HEK293 (Human embryonic kidney cells) | DMEM | 0.5-10 µg/ml |
| HeLa (Human uterine cells) | DMEM | 1-10 µg/ml |
| MEF (Mouse fibroblasts) | DMEM | 1-5 µg/ml |
Puromycin の使用文献
1. Furge KA. et al., 2001. Suppression of Ras-mediated tumorigenicity and metastasis through inhibition of the Met receptor tyrosine kinase. PNAS 98:10722-7.
2. Díaz J. et al., 2014. Rab5 is required in metastatic cancer cells for Caveolin-1-enhanced Rac1 activation, migration and invasion.. J Cell Sci. 127:2401-6.
3. Rössger K. et al., 2013. Reward-based hypertension control by a synthetic brain-dopamine interface. PNAS, 110:18150-5.